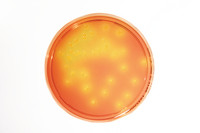

| Tên sản phẩm: | Mannitol Salt Agar – LI 30ml 120PC Merck |
| Tên gọi khác: | MSA, Chapman Medium |
| Code: | 1460230120 |
| Hãng – Xuất xứ: | Merck – Đức |
| Ứng dụng: |
– Được sử dụng để phân lập và xác định giả định Staphylococcus aureus trong dược phẩm và thực phẩm không vô trùng – Dùng làm môi trường nuôi cấy phân lập vi khuẩn, và sử dụng để sản xuất hóa chất. |
| Tính chất: |
– Hình thể: dạng rắn – Giá trị pH: 7.4 (H₂O) |
| Bảo quản: | Bảo quản ở +15°C đến +25°C. |
| Quy cách: | 120 PC / hộp |
Sản phẩm tham khảo:
| Code | Quy cách |
| 1460230020 | 20 PC / hộp |
| 1460230120 | 120 PC / hộp |

Đánh giá
Chưa có đánh giá nào.